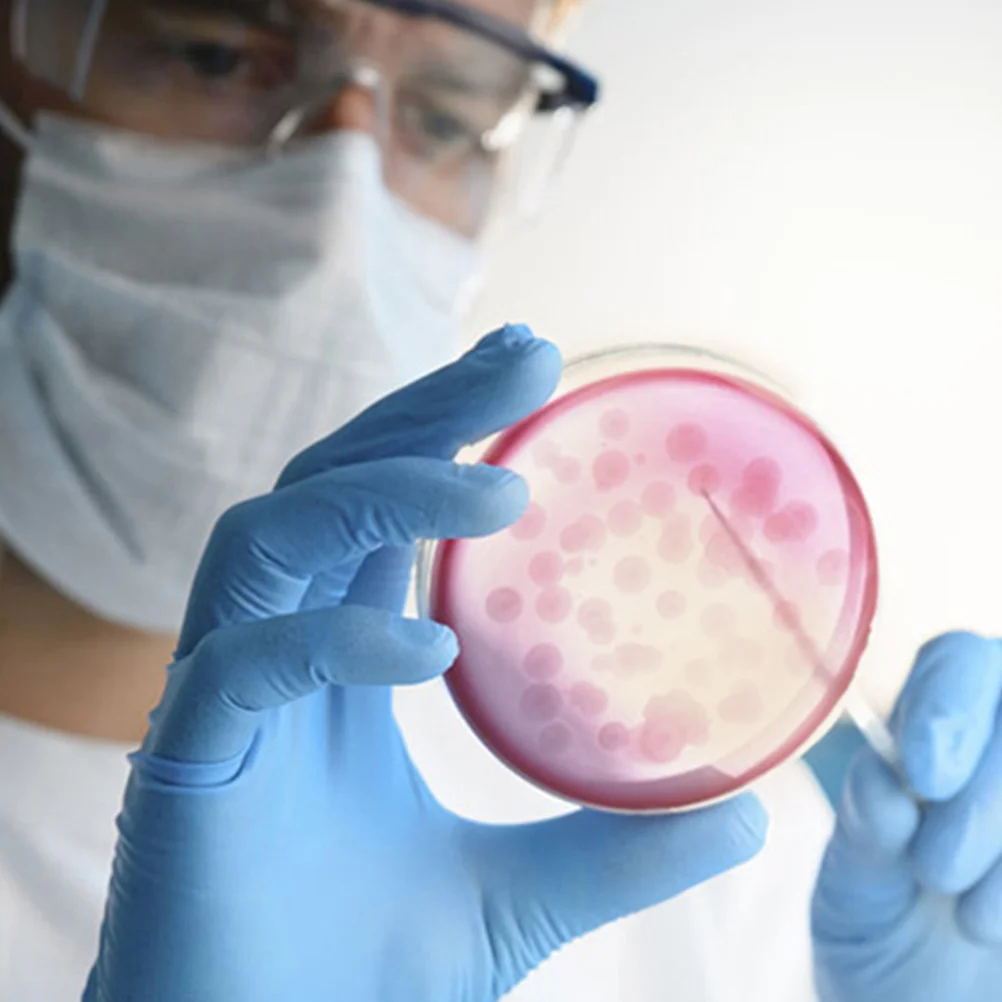
1pcs Ready-To-Use Pre-Poured Nutrient Petri Dishes Science Experiment Supplies For Laboratory Microbiology Research School

Роскошные офисные ручки, шариковые ручки для школьников, шариковая ручка с позитивной осанкой, обратно в школу, подарок, канцелярские принадлежности белый
График изменения цены & курс обмена валют
Пользователи также просматривали

1,416.23 руб.
16 Pack Dust Bags for Clean X8 Pro / X10 Pro Omni Robot Vacuum Self-Empty Station, Large Capacity Disposable Bags-A07G
aliexpress.com
4,854.63 руб.
Sweet Girls Lolita Jsk Dress Women Vintage Y2k Bow Ruffle Flyling Sleeve Party Princess Dresses Japanese Fairy Ballet Mini Dress
aliexpress.com
724.08 руб.
Hip Hop SuicideBoys group skull vintage print Hoodie Autumn Winter Unisex Casual streetwear Men Women Fleece Long sleeve Tops
aliexpress.com
5,246.61 руб.
Feathered Glacier Blue texture for iPhone15ProMax 14Pro Personality 15/14pm 13Pro drop proof phone case
aliexpress.com
7,196.13 руб.
Soft 2024 Women Handbag Leather Crossbody Capacity Large Bag _GY-W1548467285_
aliexpress.com
804.71 руб.
Сандалии принцессы Детские плиссированные, модные босоножки-гладиаторы с жемчугом, плоская подошва, однотонные, на липучке, для девочек, 2024
aliexpress.com
247.48 руб.
Комплект для прокачки тормозов Сцепления Мотоцикла и автомобиля, шланг 500 мм с односторонней трубкой клапана, комплект инструментов для прокачки тормозных вакуумных насосов, набор инструментов для прокачки
aliexpress.com
9,915.23 руб.
Лидер продаж, ICERIVER KAS KS0 ULTRA 400 г, 100 Вт, KS0 Ultra с блоком питания
aliexpress.com
38,479.40 руб.
ЛУЧШИЕ ПРОДАЖИ нового электронного аккордеона Roland V-Accordion FR-8X, оптовая цена
aliexpress.com
6,096.03 руб.
OEING Champagne Tulle Shoulder Pad Prom Dresses Mermaid PleatedEvening Dress Knee Length Formal Occasion Gown Vestidos De Noche
aliexpress.ru
481.39 руб.
Бытовые удобные мини-снэки, сварочные машины, зажимы, вакуумная машина, ручная кухонная герметизация, пищевые принадлежности, сохранитель Z0D4
aliexpress.ru
235.51 руб.
Chocola Nekopara anime girl Phone Case matte transparent For iphone 14 11 12 13 plus mini x xs xr pro max cover
aliexpress.com
5,958.00 руб.
Новые мужские крутые кожаные туфли в деловом стиле, ботильоны с круглым носком, модельные офисные короткие ботинки, мужская нескользящая повседневная рабочая обувь, размер
joom.ru
518.00 руб.
Низкотемпературный однофазный цветной гель Adricoco Low heat, №04 медовый, 30 мл
sima-land.ru
1,490.00 руб.
CASMARA Бальзам для губ восстанавливающий "UrbanProtect" 12, Бальзам для губ восстанавливающий "UrbanProtect"
letu.ru
494.45 руб.
Shock-resean Hard PC + Силиконовый Планшет с Kickstand Для Samsung Galaxy Tab A 10.1 (2019) SM-T510 (Wi-Fi) / SM-T515 (LTE)- Оранжевый, Galaxy Tab A 10.1 (2019)
tvc-mall.com
803.92 руб.
Деревянная головоломка с изображением Иисуса, пазл-головоломка с изображением дерева, головоломка с изображением Рождества, игра-головоло...
aliexpress.ru
142.10 руб.
Soft Flannel Thickened Pet Soft Fleece Pad Pet Blanket Bed Mat For Puppy Dog Cat Sofa Cushion Home Rug Keep Warm Sleeping Cover
aliexpress.com
172.25 руб.
Quicksand Жидкие Порошковые Блестки TPU Мягкий Телефон Для IPhone SE / 5S / 5 - Золото, iPhone SE (1st generation)
tvc-mall.com
973.16 руб.
Portable Mini Fan Fashion Macaron Color Mini Fan, USB Charging Neck Hanging Fan Portable Foldable Fan Hands Free Mini Fan
aliexpress.com
3,980.00 руб.
Новые кроссовки Anta Rocket 4.0 с амортизацией, противоскользящие, износостойкие, дышащие, низкие, для бега, мужские, черные 112245530-8 41
joom.com
5,998.00 руб.
Warm Pajama Nyan Big Mascot Plush Official Shark Nyan 30cm Toy, Merchandise, Approx. (Fox)
joom.com
1,777.00 руб.
Детская модная повседневная толстовка с капюшоном свободного кроя с длинными рукавами и рождественским принтом 120 белый
joom.com
1,279.00 руб.
2 шт./компл. Черные металлические настенные украшения Железное искусство Кошка Настенные подвесные украшения Подвеска-кошка Дом 2Pcs/set
joom.com
1,620.00 руб.
2025 NEW High-End Reusable Wine Saver Bottle Stopper - Vacuum Sealer and Preserver for Home Use
joom.com
1,879.00 руб.
Чехол для Motorola Edge 50 Fusion 5G из натуральной кожи спилок с кошельком и подставкой Brown
joom.com
166.05 руб.
1pcs Ready-To-Use Pre-Poured Nutrient Petri Dishes Science Experiment Supplies For Laboratory Microbiology Research School
aliexpress.ru
724.00 руб.
Набор из 9 поролоновых валиков для покраски небольших размеров, поролоновые валики, валик для покраски внутренних стен для красок на водной основе A
joom.com
30,317.00 руб.
100 листов белого картона 8,5 x 11 92 фунта 250 г/м² Картон Толстый картон Бумага Тяжелый картон для принтера Резюме Скрап United States
joom.com
1,753.00 руб.
Повседневный дорожный чемодан из полиэстера - большая вместимость для хранения спортивных вещей, многокарманный портативный, сумки для спортивного инвентаря | Сумки | Прочные дорожные сумки темно-синий
joom.com
439.00 руб.
Солнцезащитные очки без оправы в форме звезды, прозрачные солнцезащитные очки ярких цветов для вечеринок для девочек, мальчиков, женщин One Size синий
joom.com
542.06 руб.
Christmas Knitted Sweater Graffiti Tattoo Retro Vintage Sweatshirts 3DPrint Unisex Pullover Harajuku Casual Funny Long Sleeve X2
aliexpress.com
641.06 руб.
2Pcs Plastic Vase Decorative Flower Container Home Ornament Creative Vase Craft Wedding Table Desktop Display
aliexpress.ru
1,055.39 руб.
Картошка, креативная шапка с фруктами и овощами, толстая игривая шляпа месяца питания, забавная эластичная пуловерная кепка для детей и взрослых
aliexpress.ru
3,991.64 руб.
Сплошной цвет, асимметричный сетчатый топ с наклонными плечами и длинными рукавами, эластичный новый женский топ, сексуальный пуловер, блузки, футболка
aliexpress.ru











